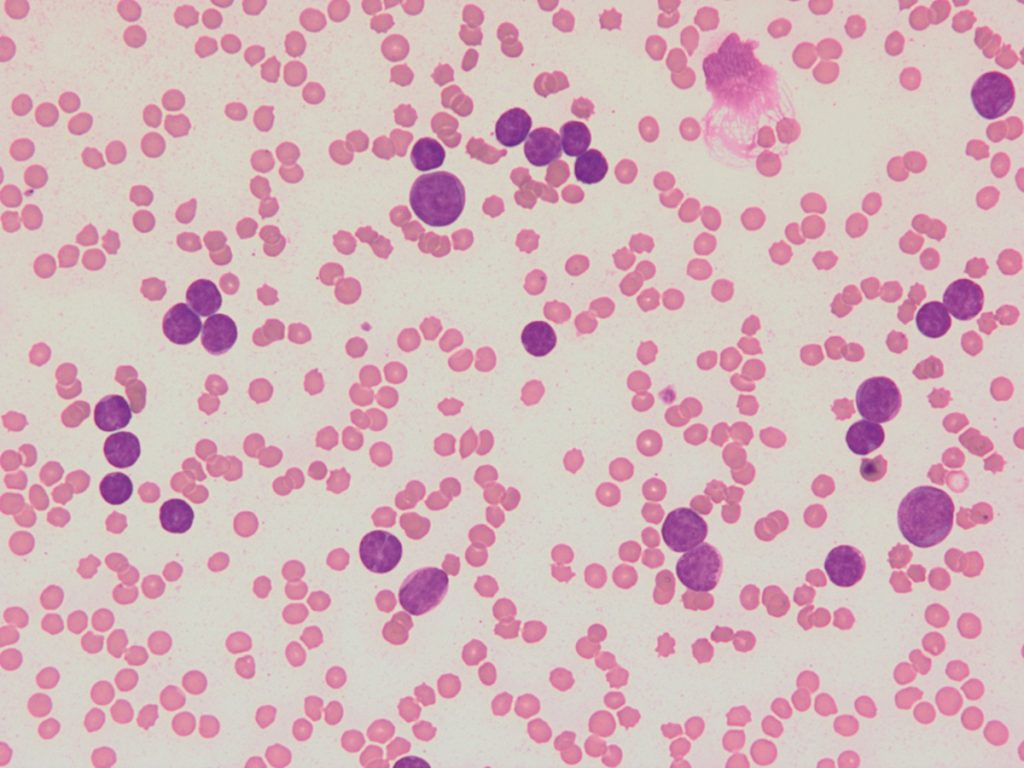
akut limfoblasztos leukémia

Az Amerikai Élelmiszer- és Gyógyszerfelügyelet (FDA) engedélyezte a leukémia (vérrák) egyes típusainak gyógyítására a Kymriah nevű immunterápiás módszert.
Az immunterápia lényege, hogy a beteg saját véréből kinyert ún. T-limfocitákat génmanipulációval olyan receptorokkal (ún. kiméra antigén receptor, CAR) látják el, melyek felismerik és elpusztítják a rákos sejteket.

Immunterápia ábra
A receptorok olyan fehérjék, amelyek más molekulával összekapcsolódva képessé válnak változásokat előidézni a sejtekben vagy azok környezetében. Azokat a géneket, melyek a felismerő receptorokat kódolják, vírusok (virális vektorok) közvetítésével juttatják be a limfocita sejtek örökítőanyagába.
A továbbiakban már olyan limfocita sejtek alakulnak ki, melyek felszínén már ott vannak ezek a felismerő receptorok. Az új receptorral rendelkező T-sejtek felismerik és megsemmisítik az akut limfoid leukémiás betegek esetében daganatossá vált B-limfocita sejteket, maguk pedig osztódva még sokáig védekeznek a rákos sejtek ellen.
A módszert gyermekeken először egy amerikai kislánynál alkalmazták, akinél semmilyen más terápia nem volt tartósan hatékony, az immunterápiával viszont már 6 éve tünetmentes.
Akut limfoblasztos leukémia mikroszkópos képe
A mostanra hivatalos engedéllyel rendelkező ún. Kymriah nevű terápia a vizsgálatban résztvevő 3-25 éves, akut limfoblastos leukémiás betegek 80 %-ánál a daganat teljes visszafejlődését eredményezte.
Sajnos a kezelésnek lehetnek súlyos mellékhatásai, embereknél immunológiai reakciók miatt kialakuló gyulladásos szövődmények, idegrendszeri problémák, epilepszia, esetleg hallucinációk kialakulását is leírták.
A kezelés 475 ezer dollárba (kb. 122 millió forint) kerül az Egyesült Államokban, és egyre nő azoknak az intézményeknek a száma, ahol a kezelés elérhető.
Ez az immunterápiás módszer utat nyithat más daganattípusok kezelésében is.
A daganatos állatok gyógykezelésében hazánkban egyelőre korlátozottak az immunterápiás lehetőségek. Amerikában már elérhető pl. kutyák és macskák számára melanoma vakcina, melyet a rosszindulatú, pigmentsejtekből kiinduló bőrdaganatok, ún. melanoma malignum kezelsére használnak.
Reméljük hazánkban is egyre több gyógyszerészeti cég indít el engedélyezési, törzskönyvezési folyamatot ilyen készítményekre, mert ahhoz, hogy ezeket itthon is használhassuk, meg kell felelni a hazai előírásoknak.
TELEFONOS ONKOLÓGIAI KONZULTÁCIÓ DAGANATOS ÁLLATOKNAK
Daganatos betegségnél minden nap számít.
Telefonon átbeszélhetjük a leleteket, második véleményt adok és személyre szabott kezelési tervet készítek – akár már 2–3 napon belül.
A konzultációhoz a korábbi leleteket kérem előre beküldeni legalább 48 órával a megbeszélt időpont előtt (e-mailben vagy futárral).







